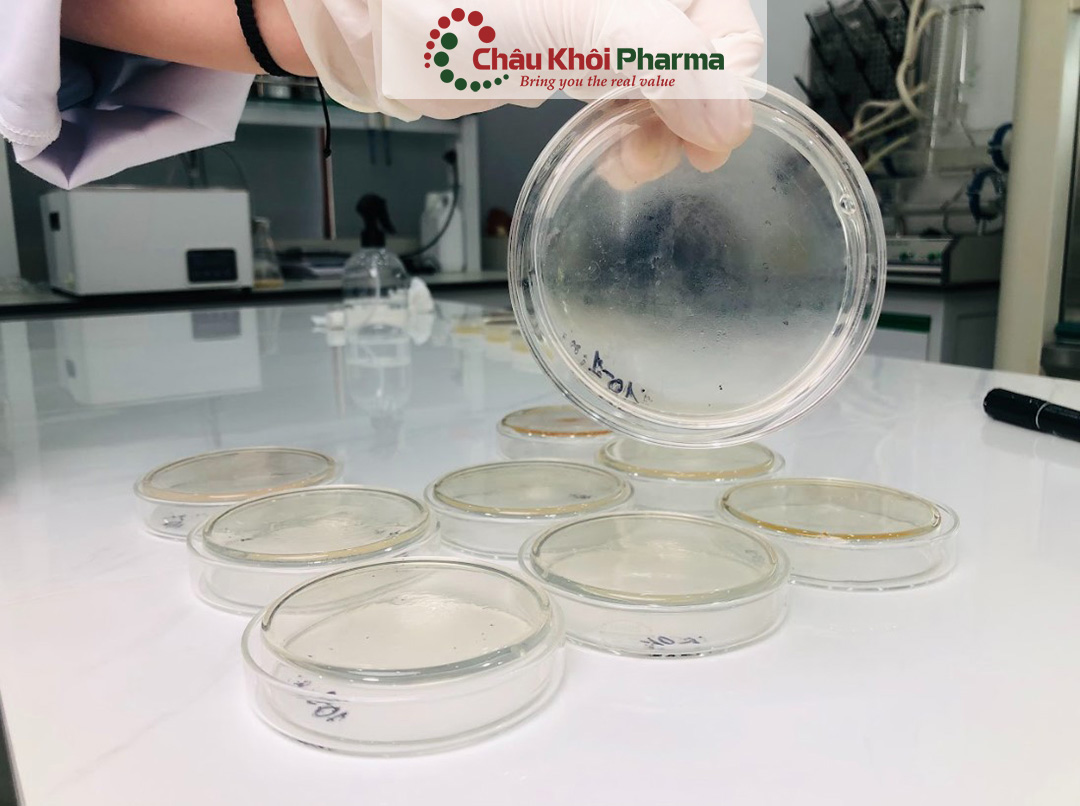
tư vấn chất lượng sản xuất sản phẩm tại Hà Nội

I. Chất lượng sản xuất sản phẩm là gì?

Chất lượng sản xuất sản phẩm được hiểu là tập hợp các đặc tính và tính năng của hàng hóa, giúp thỏa mãn nhu cầu của người tiêu dùng đồng thời đáp ứng các tiêu chuẩn kỹ thuật do ngành quy định. Đánh giá chất lượng sản phẩm không chỉ dựa trên mức độ hài lòng của khách hàng mà còn phụ thuộc vào khả năng sản phẩm đáp ứng nhu cầu cụ thể mà người tiêu dùng mong đợi.
Đối với doanh nghiệp sản xuất, chất lượng sản phẩm được xác định thông qua việc tuân thủ các tiêu chuẩn kỹ thuật và quy trình kiểm định nghiêm ngặt trước khi đưa ra thị trường. Trong khi đó, người tiêu dùng đánh giá chất lượng dựa trên độ phù hợp với mục đích sử dụng thực tế.
Theo Tổ chức Tiêu chuẩn hóa Quốc tế (ISO), chất lượng sản phẩm là tổng hợp các đặc điểm giúp sản phẩm đáp ứng nhu cầu người dùng và được thị trường đón nhận. Một sản phẩm đạt tiêu chuẩn chất lượng không chỉ đảm bảo không có lỗi mà còn phải liên tục được cải tiến để nâng cao giá trị sử dụng, mang lại lợi ích lâu dài cho khách hàng.
Xem thêm: Tư vấn công bố lưu hành mỹ phẩm uy tín tại Thanh Xuân Hà Nội
II. Các yếu tố quan trọng để đánh giá chất lượng sản xuất sản phẩm

Chất lượng sản xuất sản phẩm không chỉ ảnh hưởng đến trải nghiệm của người tiêu dùng mà còn quyết định đến uy tín và sự phát triển bền vững của doanh nghiệp. Để xác định một sản phẩm có đạt tiêu chuẩn hay không, cần dựa trên nhiều yếu tố quan trọng. Dưới đây là những tiêu chí hàng đầu giúp đánh giá chất lượng sản phẩm một cách toàn diện.
1. Hiệu suất hoạt động
Hiệu suất của sản phẩm phản ánh khả năng đáp ứng đúng chức năng và nhiệm vụ mà nó được thiết kế để thực hiện. Một sản phẩm có hiệu quả hoạt động cao không chỉ mang lại trải nghiệm tốt mà còn giúp tối ưu hóa công năng sử dụng. Ngoài ra, sản phẩm cần dễ sử dụng, thân thiện với người dùng để nâng cao giá trị thực tế khi ứng dụng vào đời sống.
2. Mức độ an toàn
An toàn là yếu tố quan trọng hàng đầu trong quá trình đánh giá chất lượng sản phẩm. Sản phẩm cần đảm bảo không gây nguy hiểm cho người sử dụng và tuân thủ các tiêu chuẩn an toàn quốc gia cũng như quốc tế. Việc đáp ứng các yêu cầu về an toàn không chỉ bảo vệ người tiêu dùng mà còn giúp doanh nghiệp tránh rủi ro pháp lý và nâng cao uy tín trên thị trường.
3. Đặc tính nổi bật
Những đặc điểm nổi bật giúp sản phẩm tạo nên sự khác biệt so với đối thủ cạnh tranh. Một sản phẩm được mô tả rõ ràng về công dụng, tính năng sẽ giúp khách hàng dễ dàng nhận biết và đánh giá giá trị của nó. Để tối ưu khả năng cạnh tranh, doanh nghiệp nên liên tục nghiên cứu, cải tiến sản phẩm nhằm đáp ứng tốt hơn nhu cầu ngày càng cao của người tiêu dùng.
4. Độ tin cậy
Sản phẩm có độ tin cậy cao là sản phẩm có thể hoạt động ổn định trong thời gian dài mà không gặp phải sự cố nghiêm trọng. Điều này đảm bảo người dùng có thể sử dụng sản phẩm mà không phải lo lắng về lỗi kỹ thuật hay hỏng hóc đột ngột. Một sản phẩm đáng tin cậy không chỉ giúp khách hàng an tâm mà còn góp phần xây dựng hình ảnh thương hiệu chuyên nghiệp và uy tín.
5. Độ bền
Độ bền thể hiện khả năng sản phẩm duy trì chất lượng trước tác động từ môi trường và các yếu tố bên ngoài. Một sản phẩm có độ bền cao giúp người tiêu dùng tiết kiệm chi phí sửa chữa, thay thế và mang lại sự hài lòng lâu dài. Với doanh nghiệp, sản phẩm bền vững giúp giảm thiểu chi phí bảo hành và nâng cao lòng tin của khách hàng.
6. Tính thẩm mỹ
Thiết kế sản phẩm không chỉ dừng lại ở tính năng mà còn cần thu hút về mặt thẩm mỹ. Yếu tố này bao gồm hình dáng, màu sắc, phong cách thiết kế và sự tiện dụng khi sử dụng. Một sản phẩm có ngoại hình bắt mắt, phù hợp với xu hướng và thị hiếu của khách hàng sẽ có lợi thế cạnh tranh cao hơn trên thị trường.
Xem thêm: Dịch vụ tư vấn công bố chất lượng mỹ phẩm chuyên nghiệp tại Thanh Xuân Hà Nội
III. Tầm quan trọng của dịch vụ tư vấn chất lượng sản xuất sản xuất sản phẩm tại Hà Nội

Trong bối cảnh thị trường ngày càng cạnh tranh, chất lượng sản phẩm đóng vai trò quan trọng trong việc xây dựng uy tín thương hiệu và gia tăng lòng tin của khách hàng. Dịch vụ tư vấn chất lượng sản xuất sản phẩm tại Hà Nội ngày càng được doanh nghiệp quan tâm, giúp tối ưu hóa quy trình sản xuất, nâng cao chất lượng sản phẩm và đảm bảo tuân thủ các tiêu chuẩn quốc tế. Dưới đây là những lý do doanh nghiệp nên sử dụng dịch vụ tư vấn chất lượng sản phẩm để phát triển bền vững.
1. Cải thiện và nâng cao chất lượng sản phẩm
Dịch vụ tư vấn chất lượng sản xuất sản phẩm tại Hà Nội doanh nghiệp xác định những điểm yếu trong sản phẩm và quy trình sản xuất. Các chuyên gia sẽ phân tích, đánh giá và đề xuất giải pháp tối ưu nhằm nâng cao chất lượng sản phẩm, đáp ứng kỳ vọng của người tiêu dùng. Khi sản phẩm được cải tiến liên tục, doanh nghiệp không chỉ gia tăng giá trị mà còn nâng cao lợi thế cạnh tranh trên thị trường.
2. Gia tăng sự hài lòng và trung thành của khách hàng
Sản phẩm có chất lượng cao giúp khách hàng tin tưởng hơn vào thương hiệu. Dịch vụ tư vấn chất lượng sản xuất sản phẩm tại Hà Nội không chỉ đảm bảo sản phẩm đáp ứng nhu cầu mà còn giúp doanh nghiệp hiểu rõ hơn về mong muốn của khách hàng. Khi sản phẩm chất lượng ổn định và phù hợp với thị hiếu, khách hàng sẽ trung thành hơn, từ đó thúc đẩy doanh số bán hàng và danh tiếng thương hiệu.
3. Tối ưu hóa quy trình sản xuất, giảm thiểu lãng phí
Một quy trình sản xuất hiệu quả sẽ giúp doanh nghiệp tiết kiệm chi phí, nâng cao năng suất và giảm thiểu lỗi kỹ thuật. Dịch vụ tư vấn chất lượng sản xuất sản phẩm tại Hà Nội sẽ phân tích từng giai đoạn trong sản xuất, từ lựa chọn nguyên liệu đến thành phẩm, giúp doanh nghiệp loại bỏ các bước không cần thiết, cải thiện hiệu suất và giảm lãng phí nguyên vật liệu.
4. Đảm bảo tuân thủ các tiêu chuẩn chất lượng và pháp lý
Mỗi ngành nghề đều có những quy định và tiêu chuẩn chất lượng riêng. Dịch vụ tư vấn chất lượng sản xuất sản phẩm tại Hà Nội giúp doanh nghiệp cập nhật các quy định mới nhất, đảm bảo sản phẩm không vi phạm pháp luật, tránh rủi ro về pháp lý và bảo vệ uy tín thương hiệu. Điều này đặc biệt quan trọng đối với những doanh nghiệp sản xuất sản phẩm xuất khẩu hoặc trong ngành thực phẩm, y tế và công nghệ.
5. Hỗ trợ phát triển sản phẩm mới, nâng cao năng lực cạnh tranh
Dịch vụ tư vấn chất lượng sản xuất sản phẩm tại Hà Nội không chỉ giúp doanh nghiệp cải tiến sản phẩm hiện có mà còn hỗ trợ trong việc nghiên cứu và phát triển sản phẩm mới. Bằng cách phân tích nhu cầu thị trường, xu hướng tiêu dùng và công nghệ sản xuất tiên tiến, doanh nghiệp có thể tạo ra những sản phẩm có tính đột phá, đáp ứng kỳ vọng khách hàng và nâng cao sức cạnh tranh trên thị trường.
6. Xây dựng lợi thế cạnh tranh lâu dài
Một doanh nghiệp có sản phẩm chất lượng cao sẽ có vị thế vững chắc trên thị trường. Thông qua dịch vụ tư vấn chất lượng, doanh nghiệp không chỉ cải tiến sản phẩm mà còn tạo ra sự khác biệt so với đối thủ. Điều này giúp gia tăng lòng tin từ khách hàng, mở rộng thị phần và nâng cao doanh thu bền vững.
Xem thêm: Tư vấn công bố chất lượng thực phẩm chức năng tại Thanh Xuân Hà Nội
IV. Châu Khôi Pharma - Đơn vị tư vấn chất lượng sản xuất sản phẩm tại Hà Nội uy tín

Khi chất lượng sản phẩm ngày càng trở thành yếu tố quyết định sự thành công của doanh nghiệp, dịch vụ tư vấn chuyên sâu đóng vai trò quan trọng trong việc đảm bảo tiêu chuẩn sản xuất. Châu Khôi Pharma tự hào là một trong những đơn vị hàng đầu cung cấp dịch vụ tư vấn chất lượng sản xuất sản phẩm tại Hà Nội, đặc biệt trong các lĩnh vực thực phẩm chức năng, thực phẩm bổ sung và mỹ phẩm. Với đội ngũ chuyên gia dày dặn kinh nghiệm hàng đầu trong lĩnh vực, bao gồm dược sĩ và tiến sĩ, Châu Khôi Pharma cam kết hỗ trợ doanh nghiệp từ giai đoạn phát triển công thức sản phẩm đến kiểm soát chất lượng và đáp ứng đầy đủ các tiêu chuẩn pháp lý.
1. Dịch vụ tư vấn chất lượng sản xuất sản phẩm tại Hà Nội gồm những gì?
Châu Khôi Pharma cung cấp giải pháp tư vấn toàn diện, giúp doanh nghiệp tối ưu hóa quy trình sản xuất và đảm bảo chất lượng sản phẩm trước khi ra mắt thị trường.
Xây dựng công thức và thành phần sản phẩm
-
Tư vấn nghiên cứu và phát triển công thức sản phẩm tối ưu, đáp ứng nhu cầu thị trường.
-
Đánh giá và đề xuất nguyên liệu đảm bảo chất lượng, hiệu quả và an toàn theo tiêu chuẩn.
Kiểm tra và đánh giá chất lượng sản phẩm
-
Hệ thống phòng thí nghiệm hiện đại giúp nghiên cứu, đánh giá sản phẩm ngay từ giai đoạn thử nghiệm.
-
Đưa ra những cải tiến cần thiết để sản phẩm đạt tiêu chuẩn chất lượng cao nhất trước khi đưa ra thị trường.
Hỗ trợ pháp lý và thủ tục công bố sản phẩm
-
Hướng dẫn doanh nghiệp chuẩn bị hồ sơ công bố sản phẩm theo đúng quy định của pháp luật.
-
Tư vấn các quy định pháp lý liên quan đến phân phối và lưu hành sản phẩm.
Kết nối với đơn vị kiểm nghiệm uy tín
-
Hợp tác với các phòng thí nghiệm được cấp phép để kiểm nghiệm sản phẩm theo tiêu chuẩn quốc gia và quốc tế.
-
Hỗ trợ theo dõi và xử lý kết quả kiểm nghiệm, đảm bảo sản phẩm đáp ứng yêu cầu chất lượng.
Đánh giá giá thành sản phẩm
-
Phân tích và so sánh chi phí sản xuất với mức giá chung trên thị trường, giúp doanh nghiệp tối ưu hóa lợi nhuận.
2. Lý do nên chọn dịch vụ tư vấn chất lượng sản xuất sản phẩm tại Hà Nội của Châu Khôi Pharma?
-
Đội ngũ chuyên gia giàu kinh nghiệm: Châu Khôi Pharma sở hữu đội ngũ chuyên gia giỏi chuyên môn, luôn cập nhật những tiêu chuẩn mới nhất trong ngành.
-
Quy trình tư vấn chuyên nghiệp: Mọi quy trình tư vấn đều tuân thủ các tiêu chuẩn khoa học và pháp lý, đảm bảo tính chính xác và đáng tin cậy.
-
Tiết kiệm thời gian & chi phí: Dịch vụ tư vấn giúp doanh nghiệp rút ngắn thời gian nghiên cứu và sản xuất, từ đó giảm chi phí và tăng tốc độ ra mắt sản phẩm.
-
Hỗ trợ tận tâm – Cam kết chất lượng: Châu Khôi Pharma không chỉ tư vấn mà còn đồng hành cùng doanh nghiệp trong suốt quá trình từ nghiên cứu đến sản xuất và phân phối sản phẩm.
Đảm bảo chất lượng sản phẩm không chỉ giúp doanh nghiệp nâng cao lợi thế cạnh tranh mà còn xây dựng lòng tin vững chắc với khách hàng. Với dịch vụ tư vấn chuyên sâu, Châu Khôi Pharma mang đến giải pháp tối ưu, giúp doanh nghiệp kiểm soát và cải thiện chất lượng sản phẩm hiệu quả. Nếu bạn đang tìm kiếm một đối tác đáng tin cậy trong lĩnh vực tư vấn chất lượng sản xuất sản phẩm tại Hà Nội, Châu Khôi Pharma sẽ là lựa chọn lý tưởng để đồng hành cùng doanh nghiệp trên con đường phát triển bền vững.




